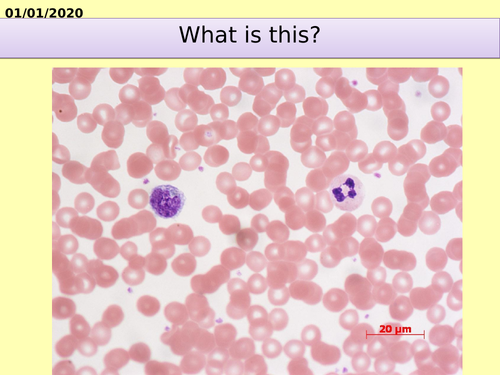
pptx, 1.03 MB

Powerpoint resources for KS4 circulatory system. Designed to be a starting point for planning of this topic, as some features (animations, boardworks materials) have been lost during transfer between devices. These are easily added in if you have access to these or similar animations/links.
Something went wrong, please try again later.
This resource hasn't been reviewed yet
To ensure quality for our reviews, only customers who have purchased this resource can review it
Report this resourceto let us know if it violates our terms and conditions.
Our customer service team will review your report and will be in touch.
£1.50